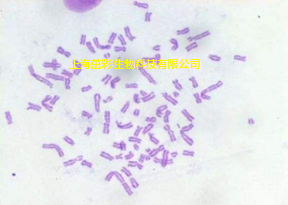
改良苯酚品红染色.png

ZC1056 改良苯酚品红染色
2022-02-28
实验收费标准:
| 项目编号 | 项目名称 | 计价单位 | 单价 |
ZC1056 | 改良苯酚品红染色 | 张 | 40元 |
实验图例展示:
实验流程:
1、取材:查阅相关植物对应的根尖分裂旺盛期,在此期间剪取新生根尖约2-3cm,纯水稍洗净。
2、预处理:用秋水仙素或者8-羟基喹啉预处理或者置于纯水中4℃处理约24h(选做)。
3、固定:取出根尖置于卡诺氏固定液(无水乙醇:冰醋酸=3:1混匀)中4℃固定约1-4h,转移根尖至75%的乙醇中保存;
4、低渗:取出根尖纯水稍洗2遍,置于纯水中浸泡约30min;
5、解离:取出根尖置于1M HCL溶液中60℃处理10-30min,纯水洗2遍,置于纯水中浸泡约30min;
6、取材染色:将根尖用纯水清洗2遍后置于载玻片上,切取根尖分生区并拨散,组画笔画圈,晾干或者稍烤干分生区组织细胞,滴加改良苯酚品红染液染色15-35min。
7、压片:直接用染色液封片,稍吸除多余的染色液,盖玻片上覆盖滤纸,用橡皮擦或者手指平整地按压玻片进行压片,分散染色体;
8、封片:将制好的玻片放置-20℃下冰冻约10min,取出后用刀片从盖玻片一角迅速撬开,晾干或烤干载玻片和盖玻片,甘油明胶或中性树胶封片。
9、显微镜镜检,图像采集分析。
结果判读:
染色体呈深的紫红色,背景浅的紫红色或者无色。
注意事项:
1.若固定后的根尖暂时不使用,保存在75%的乙醇中,下次使用前需要再次固定,4℃条件下约4h。
2.压片过程中,防止盖玻片移动或者破裂,得到数量清晰的染色体,此步骤操作较难成功。
3.改良苯酚品红染色液阴凉通风处可保存1年不变质。